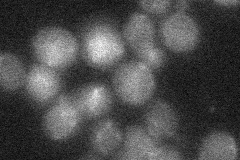
YFL040W
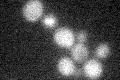
YFL040W

View description
Putative transporter, member of the sugar porter family; YFL040W is not an essential gene
Localization:
Intensity:
Fold change:
Significance:
-
C’ GFP library in SD

below threshold15.25 -
N' NOP1pr-GFP in SD

vacuole31.6351 -
N' TEF2pr-mCherry in SD

vacuole58.5594 -
N' NATIVEpr-GFP in SD
below threshold17.5891 -
N' TEF2pr-VC and Cyto-VN in SD

below threshold22.1357 -
C’ GFP library in SD+DTT

cytosol15.331No -
C’ GFP library in SD+H2O2
cytosol14.230.93No -
C’ GFP library in Starvation Media

cytosol18.381.2No -
C’ GFP library on the background of Pup2-DaMP

N/A -
C’ GFP library on the background of CCT mutant

N/A0N/AYes
